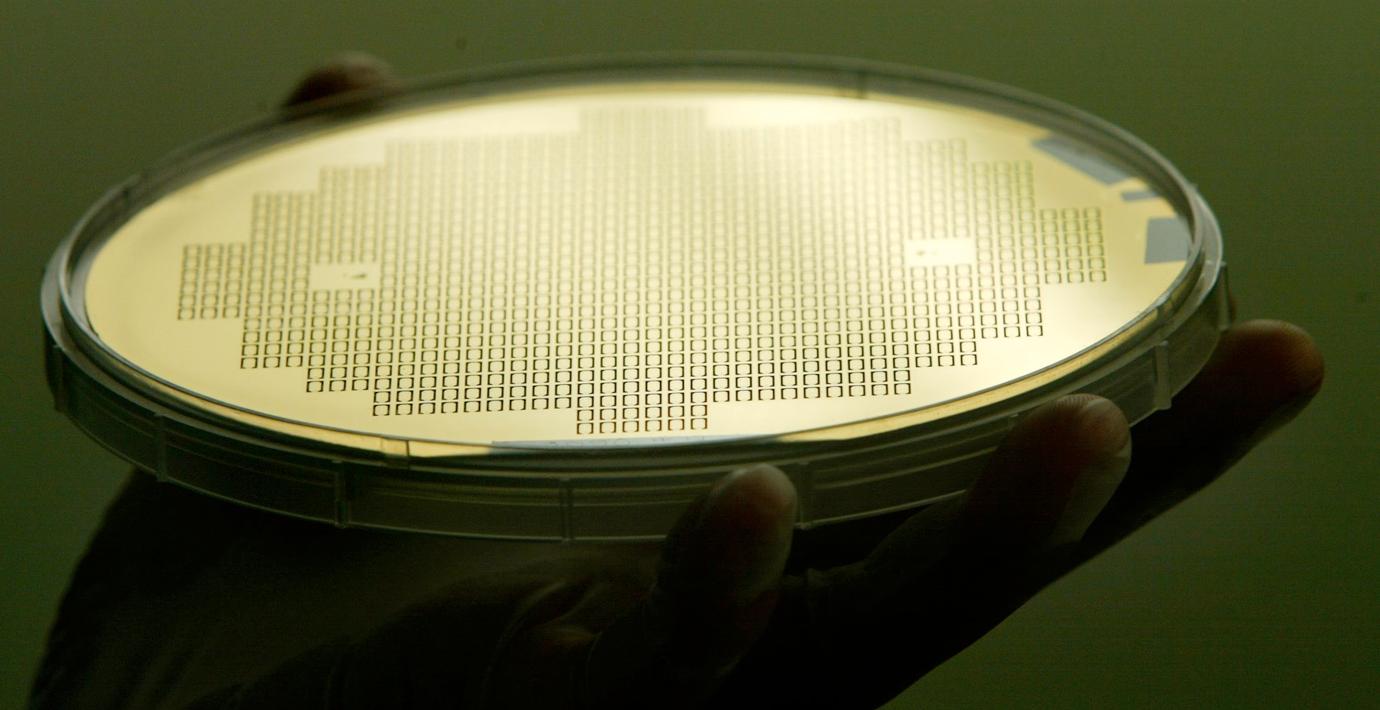

Järfälla ber regeringen om hjälp att stoppa Kinabolag
Det kinesiskägda halvledarföretaget Silex Microsystems har ansökt om bygglov för en anläggning i Järfälla kommun. Nu vädjar lokala politiker från bägge sidor blockgränsen om hjälp från regeringen att stoppa företagets byggplaner i en gemensam debattartikel i DN.
Enligt debattörerna har bolaget kopplingar till den kinesiska statens säkerhetspolitiska ambitioner varmed expansionsplanerna i kommunen utgör ett hot mot Sveriges säkerhet. Trots detta finns ingen laglig möjlighet för kommunen att avslå bolagets bygglovsansökan.
”Vi kan inte låta bli att reagera på de allvarliga uppgifter som florerar”, skriver debattörerna Eva Ullberg (S) och Emma Feldman (M), ordförande respektive första vice ordförande i Järfällas kommunstyrelse.
Silex Microsystems grundades i Sverige och har varit etablerat i Järfälla sedan flera decennier. Vd:n Edvard Kälvesten har tidigare sagt till tidningen Mitti att de kinesiska ägarna inte har något inflytande över verksamheten.